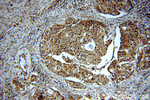
CDK1 Antibody in Immunohistochemistry (Paraffin) (IHC (P))

Search
Proteintech
CDK1 Polyclonal Antibody
{{$productOrderCtrl.translations['antibody.pdp.commerceCard.promotion.promotions']}}
{{$productOrderCtrl.translations['antibody.pdp.commerceCard.promotion.viewpromo']}}
{{$productOrderCtrl.translations['antibody.pdp.commerceCard.promotion.promocode']}}: {{promo.promoCode}} {{promo.promoTitle}} {{promo.promoDescription}}. {{$productOrderCtrl.translations['antibody.pdp.commerceCard.promotion.learnmore']}}
产品信息
19532-1-AP
种属反应
已发表种属
宿主/亚型
分类
类型
抗原
偶联物
形式
浓度
规格
纯化类型
保存液
内含物
保存条件
运输条件
产品详细信息
The antibody is specific to the 2 isoforms of CDC2.
靶标信息
CDK1 or Cell Division Control protein 1 is essential for the completion of START, the controlling event in the cell cycle that is required to initiate mitosis. CDK1 is a catalytic subunit of a protein kinase complex, called the M-Phase Promoting Factor that induces entry into mitosis and is universal among eukaryotes. Phosphorylation of Bcl-2 in G2/M phase-arrested cells following photodynamic therapy with hypericin involves a CDK1-mediated signal and delays the onset of apoptosis. Therapeutic potential of CDK inhibitor NU2058 in androgen-independent prostate cancer has also been demonstrated.
仅用于科研。不用于诊断过程。未经明确授权不得转售。
生物信息学
蛋白别名: ABL1; CDK1; cell cycle controller CDC2; cell cycle p34 CDC2 kinase protein; Cell division control protein 2 homolog; cell division cycle 2 homolog A; cell division cycle 2, G1 to S and G2 to M; Cell division cycle control protein 2; cell division cycle control protein 2a; Cell division protein kinase 1; Cyclin-dependent kinase 1; DKFZp686L20222; KCIP-1; MGC111195; MGC53829; OTTHUMP00000019660; P34 CDK1; P34 MGC111195; p34 protein kinase; Protein 1054; unnamed protein product
基因别名:
CDC2; CDC28A; Cdc2a; CDK1; CDKN1; p34
UniProt ID: (Human) P06493, (Rat) P39951, (Mouse) P11440
Entrez Gene ID: (Human) 983, (Rat) 54237, (Mouse) 12534